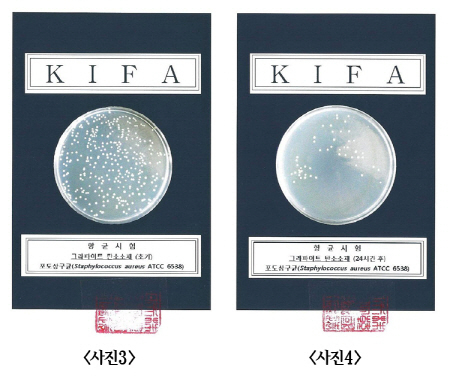
NSP통신-향균시험결과, 시트실험 전(왼쪽 사진3)과 후(사진4).

업앤다운
게임주 상승…펄어비스↑·조이시티↓

[서울=DIP통신] 황기대 기자 = 스마트폰 발열잡는 스티커로 잘 알려진 쿨링패드인 ‘쿨패드(CoolPad)’가 원적외선에 이어 향균효과도 있는 것으로 밝혀졌다.
알리바바에 따르면, 꿈의 소재인 ‘그래핀’의 그라파이트 탄소소재로 만든 쿨패드가 대장균과 포도상구균 등을 감소시켜주는 향균효과가 있다.
현재 쿨패드를 유통판매하고 있는 알리바바는 한국원적외선협회 부설 한국원적외선응용평가연구원의 시험성적서를 인용해 대장균에 의한 향균시험에서 89.4%의 향균효과를 나타냈다고 설명했다.
또한, 포도상구균에 의한 향균시험에서도 86%의 정균감소가 있었다고 밝혔다.
알리바바 관계자는 “8월부터 본격적으로 판매를 시작한 쿨패드가 향균효과까지 있는 것으로 밝혀져 그 동안 일상생활에서 흔히 뭍어 나올 수 있는 아이폰, 갤럭시S 등의 스마트폰 세균 등을 조금이나마 감소시킬 수 있게 됐다”면서 “쿨패드 하나로 방열, 전자파차단, 향균까지 3가지 기능을 모두 이용할 수 있다”고 말했다.
한편, 온라인쇼핑몰 알리바바쇼핑몰(www.b2balibaba.com)을 통해 판매되고 있는 쿨패드는 예약 판매 결과, 1만명 이상의 소비자들이 구매 또는 관심도를 보였다.
gidae@dipts.com
<저작권자ⓒ 소비자가 보는 경제뉴스 DIP통신. 무단전재-재배포 금지.>